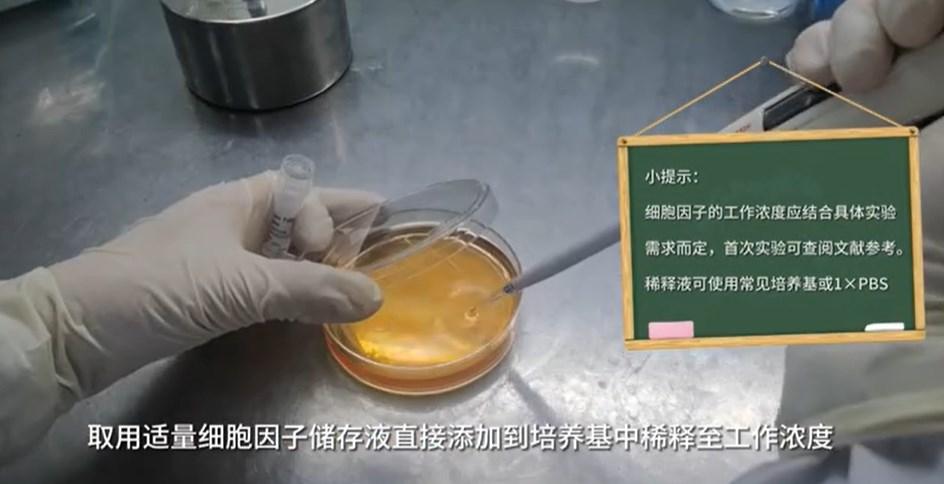

细胞因子使用方法详解

Abbkine细胞因子均由重组蛋白冻干粉及配套复溶buffer组成。
注意:不同产品复溶buffer成分有所差异,不建议混合使用

图1. Abbkine细胞因子产品组成
首先使用前检查产品状态(冻干粉状)
第一步:开盖前离心
开盖前务必离心,将管壁的冻干粉离心至管底,离心条件10000 rpm离心30-60s或4000 rpm离心5 min

图2. 开盖前离心
第二步:复溶获得储存液
细胞因子冻干粉为无菌生产,复溶时超净工作台内无菌操作。
推荐使用配套复溶buffer对离心后的冻干粉进行复溶。复溶过程中,用枪吹打混匀即可,避免剧烈涡旋震荡,否则有可能影响细胞因子的活性,储存液浓度参考说明书推荐控制在0.1-1mg/ml,可根据产品规格对复溶buffer用量进行计算。
举例:如订购5ug规格冻干粉,复溶时添加50ul 复溶buffer获得0.1mg/ml储存液。
注意:禁止略过复溶步骤直接将冻干粉稀释为低浓度工作液,否则可能导致无法完全溶解,造成损失。
第三步:稀释为工作液
使用稀释液(如:培养基或1×PBS)将储存液进一步稀释为工作液,也可取适量复溶后的储存液直接添加至培养基中用于细胞培养。细胞因子的工作浓度应结合具体实验需求而定,首次实验可查阅参考文献。
图3. 稀释为工作液
第四步:添加载体蛋白溶液长期储存
向储存液中添加终浓度为10% FBS载体蛋白溶液。已溶解的细胞因子在4℃可保存1周,添加载体蛋白后可分装于-20℃或-80℃长期保存。
注意:分装冻存时,需保证蛋白浓度不低于10μg/ml,而且每管中的溶液体积不小于10 μl !
常见的含载体蛋白溶液:
0.1% BSA(牛血清白蛋白)
10% FBS(胎牛血清)
5% HSA(人血清白蛋白)

图4. 添加终浓度为10% FBS载体蛋白溶液

产品推荐(点击货号可以直接进入产品详情页)
产品编号 | 产品名称 | 规格 |
Ulp1 (SUMO Protease /Ulp1 peptidase) | 500 U/1000 U/5000 U | |
Terminal Deoxynucleotidyl Transferase (TdT) | 40 μg/100 μg | |
Human Annexin V/ANXA5 protein | 100 μg/1 mg/10 mg | |
Luciferase firefly | 5 mg/25 mg | |
Mouse IL-4 protein | 5 μg/20 μg/100 μg/1 mg | |
Human TGF-β protein | 5 μg/20 μg/100 μg/1 mg | |
Recombinant GM-CSF,Mouse,AF | 5 μg/20 μg/100 μg/1 mg | |
Human FGF-2(154 aa)protein | 20 μg/100 μg/500 μg/1 mg | |
Mouse IFN-γ | 20 μg/100 μg/500 μg/1 mg | |
Human IL-4 Protein, His tag (Animal-Free) | 5 μg/20 μg/100 μg/1 mg | |
Human EGF protein | 100 μg/500 μg/1 mg/10 mg | |
Mouse IL-1 beta Protein, His tag (Animal-Free) | 5 μg/20 μg/100 μg/1 mg | |
Mouse RANKL protein | 2 μg/10 μg/100 μg/1 mg | |
Mouse/Rat TGF beta 1, His tag (Animal-Free) | 5 μg/20 μg/100 μg/1 mg | |
Mouse TNF-α protein | 5 μg/20 μg/100 μg/1 mg | |
Human IL-6 Protein, His tag (Animal-Free) | 5 μg/20 μg/100 μg/1 mg | |
Human IFN-γ protein | 20 μg/100 μg/500 μg/1 mg | |
Recombinant IL-1 beta,Human,AF | 5 μg/20 μg/100 μg/1 mg | |
Human IL-13 protein | 5 μg/20 μg/100 μg/1 mg | |
Mouse M-CSF protein | 5 μg/20 μg/100 μg/1 mg | |
Human IL-10 protein | 5 μg/20 μg/100 μg/1 mg | |
Huamn RANKL protein | 5 μg/20 μg/100 μg/1 mg | |
Human VEGF165 protein | 5 μg/20 μg/100 μg/1 mg |
欢迎广大“蝌蚪”们多多关注Abbkine公众号,还会有更多科研惊喜等着大家哟。同时,Abbkine的技术专家为了给广大读者提供学习生物知识的平台,经过不懈努力,将多种高端生物实验的干货整理出来,后期陆续在微信公众号中刊登,请广大热爱科学的读者持续关注Abbkine公众号。
Abbkine致力于为广大科研用户提供高品质,高性价比的科研试剂!
想要了解更多实验干货,敬请关注Abbkine 微信公众号及视频号!
我们将持续更新更多技术前沿资讯,敬请期待!
赋能细胞研究与治疗 Enabling cell research and therapy
亚科因生物技术有限公司(Abbkine Biotechnology Co., Ltd)成立于2017年,总部位于中国武汉。公司致力于细胞科研检测及细胞治疗领域关键试剂的研发、生产和销售,成为全球细胞制药领域创新的关键推动者。公司主营业务包括细胞培养、扩增及储存试剂,细胞代谢、检测及分选试剂盒,细胞治疗用原料及细胞因子等产品及定制化服务。围绕生物试剂研发,亚科因生物已建立了稳定完善的两大关键技术平台:生化试剂配方和重组蛋白表达进化平台,为细胞科研检测及细胞治疗核心试剂的高通量、高效率研发生产提供保障。


